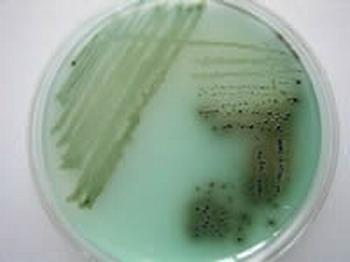

小儿沙门氏菌感染吃什么药好,小儿沙门氏菌感染怎么预防。小儿沙门氏菌感染怎么办呢,很多人只是听说过小儿沙门氏菌但是并不是知道这是什么,具体的病因是什么,怎么避免生病呢,小编为大家带来了关于小儿沙门氏菌感染的预防方法。
沙门氏菌的前世今生
在遥远的19世纪,美国爆发了一场大规模的猪霍乱疫情,当时有个著名的科学家叫沙门,他从病猪的肠道内分离得到一种前所未见的细菌,于是起名叫沙门氏菌。
科学家经过研究发现,它就像一种打不死的小强,能在恶臭的粪便和污水中存活1~2个月,在牛奶、肉蛋类食品中存活长达数月,因此抵抗力差的宝宝很容易通过吃受污染的食物或水而引起爆发性的流行。世界卫生组织也公认沙门氏菌感染是腹泻的四大全球病因之一!
成人若感染沙门氏菌多数无需抗生素治疗,通常在发热72小时内就可自行好转,但对于免疫功能差的婴儿,在感染沙门氏菌后会出现发热、恶心、呕吐、腹泻、腹痛等一系列的症状。
由于抵抗力差,还可能出现危及生命的菌血症和严重脱水,少数还可合并脑膜炎或骨髓炎。
沙门氏菌感染吃什么药好
一般采用喹诺酮类抗生素如环丙沙星、氧氟沙星均有较好的治疗效果。
怎么预防沙门氏菌感染呢?
世界卫生组织(WHO)在预防沙门氏菌感染中曾出过一个食品安全5大要点的科普动画,既生动活泼还寓教于乐,宝妈可以带着宝宝一起来看看学习一下:
1.保持清洁
饭前便后、接触食物前都要记得洗手,接触宠物、农场动物、生鸡蛋后也要仔细洗净双手。
2.生熟食品分开
处理生食和熟食的砧板要分开以避免交叉污染,处理蔬菜和肉类的砧板要分开,比如用正面切菜,反面切肉。
3.彻底做熟食物
沙门氏菌的最大特点是耐寒不耐热,因此即使你把食物放冰箱,它依然能活得自在,但如果加热至50~60℃、10多分钟就可以把它杀死,煮沸的话可立即将它杀灭。
因此一定要保证食物彻底做熟再吃,尤其是肉、蛋类食物,比如半生不熟的鸡蛋、7分熟的牛排,还是免了吧!
4.在安全的温度下保存食物
暂时不吃的食物用保鲜膜包好放到冰箱冷藏,等再次吃时务必充分加热。
5.使用安全的水和食物原料
避免饮用未消毒奶或使用由未消毒奶制成的产品,仅饮用经巴氏消毒或煮沸的牛奶。如果外出旅游时不确定饮用水是否安全,可以买瓶装矿泉水。
当孩子出现腹泻(大量水样便),腹痛,里急后重感,呕吐,发热等症状时立即就医!